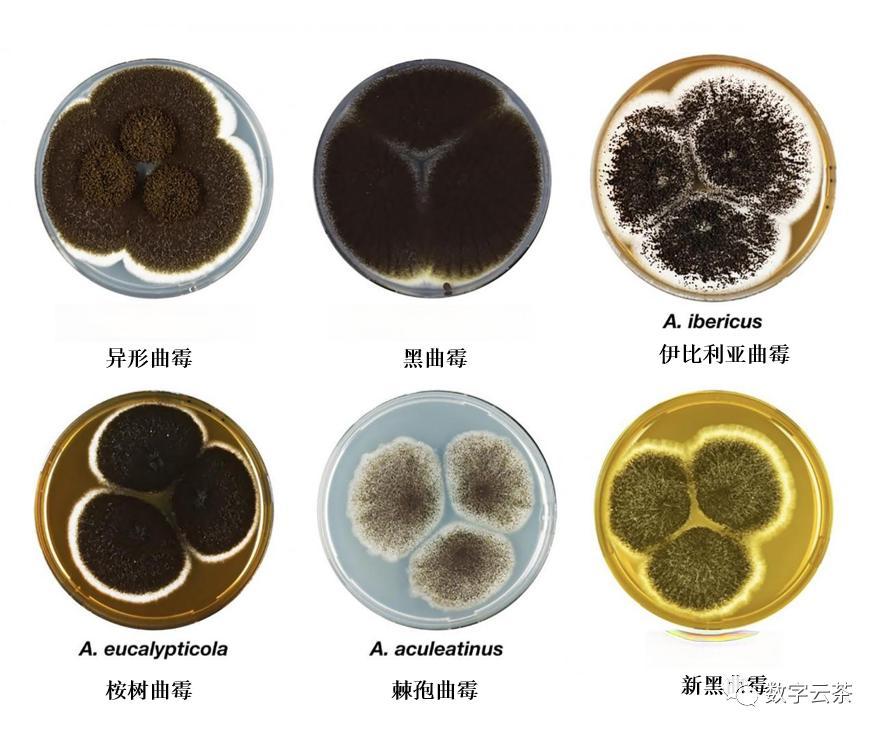
Image

发酵过程中,微生物对普洱茶品质的影响
发布时间:2024-09-16
普洱茶的醇厚口感和独特香气背后,隐藏着一个微观世界的奥秘。在这个被称为“微生物园”的世界里,各种看不见的“制茶大师”正默默塑造着普洱茶的品质。研究表明,普洱茶发酵过程中涉及的微生物种类繁多,包括霉菌、酵母菌、细菌等,它们共同构成了一个复杂的生态系统。
黑曲霉是普洱茶发酵过程中的“主角”之一。它能产生多种水解酶,如葡萄糖淀粉酶、纤维素酶等,这些酶能够分解茶叶中的大分子物质,使茶叶内含物更容易渗出。同时,黑曲霉产生的多酚氧化酶可以降低茶多酚含量,减少普洱茶的苦涩味道。更重要的是,黑曲霉发酵的普洱茶香气独特,沉香中带有花果香气,为普洱茶增添了独特的风味。
酵母菌在普洱茶发酵过程中也扮演着重要角色。它们主要通过发酵作用,将茶叶中的碳水化合物转化为酒精和二氧化碳。这个过程不仅改善了茶叶的口感,还使茶叶更加浓郁和柔和。研究发现,普洱茶中的酵母菌种类繁多,包括Blastobotrys adeninivorans、酿酒酵母(Saccharomyces cerevisiae)等。
乳酸菌是另一个值得关注的微生物。它们能够产生大量的乳酸,改变茶叶的酸碱性,同时还能分解茶叶中的部分有机酸和挥发性物质,增加茶叶的风味。研究表明,乳酸菌在普洱茶发酵过程中能够转化出丰富的有机酸,如乳酸、葡萄糖酸等,使茶叶味道更加醇美。
随着发酵的进行,普洱茶中的微生物群落也在不断变化。研究显示,普洱茶发酵初期以细菌为主,中期霉菌占优势,后期酵母菌数量增加。这种动态变化直接影响了普洱茶的品质形成。例如,在发酵初期,细菌通过产酸来减少茶叶的pH值,改变茶叶的化学组成;中期霉菌大量繁殖,分解茶叶中的纤维素和蛋白质;后期酵母菌活跃,进一步改善茶叶的口感和香气。
微生物对普洱茶品质的影响是全方位的。它们不仅改变了茶叶的化学成分,如茶多酚、儿茶素和茶黄素含量大幅减少,没食子酸、茶红素和茶褐素大量增加,还塑造了普洱茶独特的风味和香气。更重要的是,微生物发酵过程中的代谢产物,如洛伐他汀等,赋予了普洱茶调节糖类代谢、降脂减肥等健康功效。
普洱茶的发酵过程,本质上是一个微生物驱动的生物转化过程。在这个过程中,各种微生物相互作用,共同塑造了普洱茶的品质。未来,通过深入研究这些微生物的作用机制,我们有望开发出更安全、更稳定的普洱茶发酵技术,为消费者带来更优质的普洱茶产品。